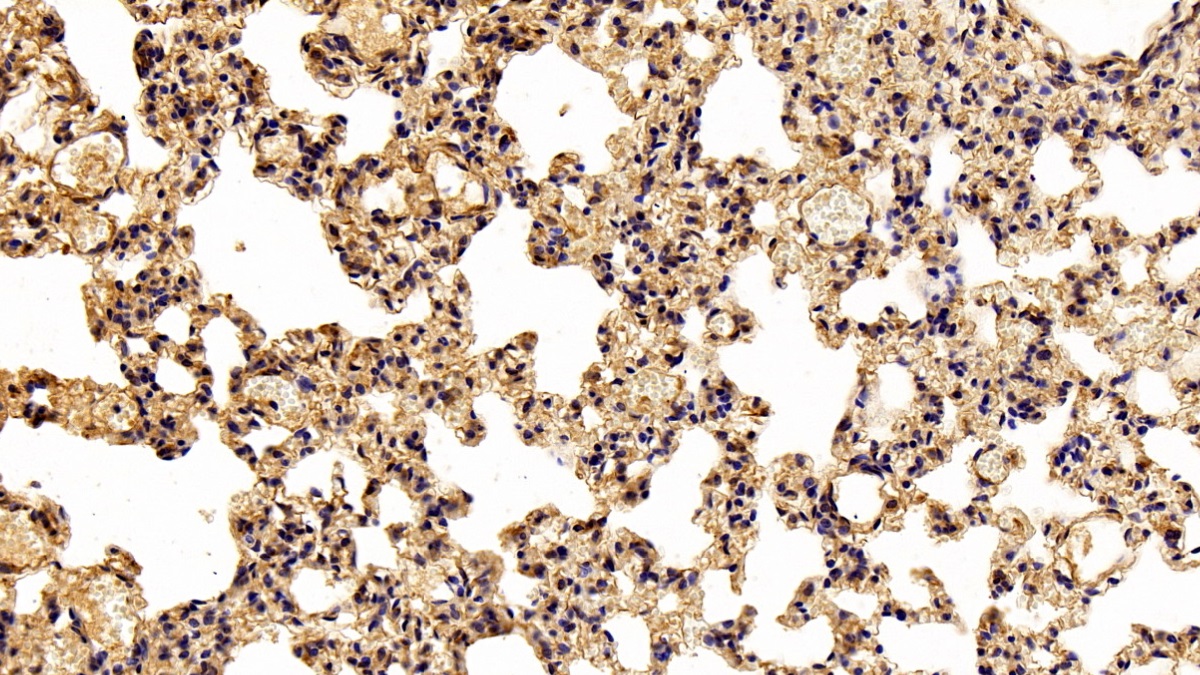

Polyclonal Antibody to Nitric Oxide Synthase 2, Inducible (NOS2) 

NOS2A; INOS; HEP-NOS; I-NOS; Hepatocytes Oxide Synthase; Peptidyl-cysteine S-nitrosylase NOS2
Overview
Properties
- Product No.PAA837Ra02
- Organism SpeciesRattus norvegicus (Rat) Same name, Different species.
- ApplicationsWB; IHC
If the antibody is used in flow cytometry, please check FCM antibodies.
Research use only - DownloadInstruction Manual
- CategoryEnzyme & KinaseMetabolic pathwayTumor immunityCardiovascular biology
- SourcePolyclonal antibody preparation, Host Rabbit
- Ig Type IgG, Potency n/a
- PurificationAntigen-specific affinity chromatography followed by Protein A affinity chromatography
- LabelNone
- Immunogen RPA837Ra02-Recombinant Nitric Oxide Synthase 2, Inducible (NOS2)
- Buffer FormulationPBS, pH7.4, containing 0.02% NaN3, 50% glycerol.
- TraitsLiquid, Concentration 0.5mg/mL
Sign into your account
Share a new citation as an author
Upload your experimental result
Review

Contact us
Please fill in the blank.
Specifity
The antibody is a rabbit polyclonal antibody raised against NOS2. It has been selected for its ability to recognize NOS2 in immunohistochemical staining and western blotting.
Usage
Western blotting: 0.01-2µg/mL;
Immunohistochemistry: 5-30µg/mL;
Optimal working dilutions must be determined by end user.
Storage
Store at 4°C for frequent use. Stored at -20°C in a manual defrost freezer for two year without detectable loss of activity. Avoid repeated freeze-thaw cycles.
Stability
The thermal stability is described by the loss rate. The loss rate was determined by accelerated thermal degradation test, that is, incubate the protein at 37°C for 48h, and no obvious degradation and precipitation were observed. The loss rate is less than 5% within the expiration date under appropriate storage condition.
Organism Species More: Mus musculus (Mouse)Giveaways
Increment services
-
 Antibody Labeling Customized Service
Antibody Labeling Customized Service
-
 Protein A/G Purification Column
Protein A/G Purification Column
-
 Staining Solution for Cells and Tissue
Staining Solution for Cells and Tissue
-
 Positive Control for Antibody
Positive Control for Antibody
-
 Tissue/Sections Customized Service
Tissue/Sections Customized Service
-
 Phosphorylated Antibody Customized Service
Phosphorylated Antibody Customized Service
-
 Western Blot (WB) Experiment Service
Western Blot (WB) Experiment Service
-
 Immunohistochemistry (IHC) Experiment Service
Immunohistochemistry (IHC) Experiment Service
-
 Immunocytochemistry (ICC) Experiment Service
Immunocytochemistry (ICC) Experiment Service
-
 Flow Cytometry (FCM) Experiment Service
Flow Cytometry (FCM) Experiment Service
-
 Immunoprecipitation (IP) Experiment Service
Immunoprecipitation (IP) Experiment Service
-
 Immunofluorescence (IF) Experiment Service
Immunofluorescence (IF) Experiment Service
-
 Buffer
Buffer
-
 DAB Chromogen Kit
DAB Chromogen Kit
-
 SABC Kit
SABC Kit
-
 Long-arm Biotin Labeling Kit
Long-arm Biotin Labeling Kit
-
 Real Time PCR Experimental Service
Real Time PCR Experimental Service
Citations
- High-molecular weight hyaluronan reduced renal PKC activation in genetically diabetic micePubMed: 20713153
- Hyaluronan reduces inflammation in experimental arthritis by modulating TLR-2 and TLR-4 cartilage expressionScienceDirect: S0925443911001323
- Adenosine A2a Receptor Activation and Hyaluronan Fragment Inhibition Reduce Inflammation in Mouse Articular Chondrocytes Stimulated with Il-1betaWiley: source
- Hyaluronan in part mediates IL-1beta-induced inflammation in mouse chondrocytes by up-regulating CD44 receptorsScienceDirect: S0378111911007347
- A Novel Mechanism of Formaldehyde Neurotoxicity: Inhibition of Hydrogen Sulfide Generation by Promoting Overproduction of Nitric OxidePubMed: 23359814
- Regulation of Microglia Activity by Glaucocalyxin-A: Attenuation of Lipopolysaccharide-Stimulated Neuroinflammation through NF-κB and p38 MAPK Signaling PathwaysPlosOne: Source
- The inhibition of hyaluronan degradation reduced pro-inflammatory cytokines in mouse synovial fibroblasts subjected to collagen-induced arthritis.PubMed: 22234777
- Amentoflavone inhibits iNOS, COX-2 expression and modulates cytokine profile, NF-κB signal transduction pathways in rats with ulcerative colitisPubmed: 24126114
- Decalepis hamiltonii inhibits tumor progression and metastasis by regulating the inflammatory mediators and nuclear factor κB subunitsPubmed: 24013642
- Inhibition of UVB-induced skin phototoxicity by a grape seed extract as modulator of nitrosative stress, ERK/NF-kB signaling pathway and apoptosis, in SKH-1 micePubmed: 23567245
- Age-related changes in ADMA–DDAH–NO pathway in rat liver subjected to partial ischemia followed by global reperfusionScienceDirect: S0531556513003331
- Protective effect of marine mangrove Rhizophora apiculata on acetic acid induced experimental colitis by regulating anti-oxidant enzymes, inflammatory mediators and nuclear factor-kappa B subunitsScienceDirect: S1567576913004153
- L-ARGININE, BUT NOT L-NAME PROTECTS AGAINST LIVER INJURY INDUCED BY EXPERIMENTAL ISCHEMIA-REPERFUSIONTdmu:Source
- Effects of topically applied tocotrienol on cataractogenesis and lens redox status in galactosemic ratsPubmed:24940038
- Protective Effect of?Acacia ferruginea?against Ulcerative Colitis via Modulating Inflammatory Mediators, Cytokine Profile and NF-κB Signal Transduction PathwaysPubmed:24941292
- Utility of Apc-mutant rats with a colitis-associated colon carcinogenesis model for chemoprevention studiesPubmed:25222193
- Beta-arrestin 1 is involved in the catabolic response stimulated by hyaluronan degradation in mouse chondrocytesPubmed:25673209
- Modulating effect of Biophytum sensitivum extract on rats with acetic acid-induced ulcerative colitisPubmed:5243883
- Resveratrol ameliorates oxidative stress and inhibits aquaporin 4 expression following rat cerebral ischemia-reperfusion injuryPubMed: 26458999
- Apocynin protects against ethanol-induced gastric ulcer in rats by attenuating the upregulation of NADPH oxidases 1 and 4PubMed: 26522475
- Protective Effect ofPubMed: 26349607
- Acacia ferruginea inhibits inflammation by regulating inflammatory iNOS and COX-2PubMed: 25738525
- Circulating CD14+HLA-DR-/low myeloid-derived suppressor cells in leukemia patients with allogeneic hematopoietic stem cell transplantation: novel clinical potential strategies for the prevention and cellular therapy of graft-versus-host diseasePubmed:27109254
- Anti-oxidative, anti-secretory and anti-inflammatory activities of the extract from the root bark of Lycium chinense (Cortex Lycii) against gastric ulcer in micePubmed:26972100
- Toxoplasma gondii GRA15II effector-induced M1 cells ameliorate liver fibrosis in mice infected with Schistosomiasis japonicaPubmed:27157496
- Роль индуцибельной NO-синтазы в механизмах регуляции функциональной активности кальций-активируемых калиевых каналов коронарных сосудов у крыс, адаптированных к стрессуarticle:n
- Role of RhoA/MERK1/ERK1/2/iNOS signaling in ocular ischemic syndromepubmed:27538909
- Influences of Hyriopsis cumingii polysaccharides on mice immunosignaling molecules and T lymphocyte differentiation09540105.2017.1306494
- Mechanism of the anticataract effect of liposomal MgT in galactose-fed rats.pubmed:27440992
- Anti-oxidative, anti-secretory and anti-inflammatory activities of the extract from the root bark ofLycium chinense (Cortex Lycii) against gastric ulcer in mice.pubmed:26972100
- Protective Effect of Zingiber officinale Against Dalton's Lymphoma Ascites Tumour byRegulating Inflammatory Mediator and Cytokines.pubmed:27435276
- Posttraumatic Stress Disorder Disturbs Coronary Tone and Its Regulatory Mechanismspubmed:28676988
- Immunomodulatory Activities of a Fungal Protein Extracted from Hericium erinaceus through Regulating the Gut Microbiotapubmed:28713364
- Protective effect of Averrhoa bilimbi L. fruit extract on ulcerative colitis in wistar rats via regulation of inflammatory mediators and cytokinespubmed:28531922
- Anti-ulcerogenic effect of KFP-H008 against ethanol-induced gastric ulcer via p38 MAPK/NF-κB pathway10.1039/C7RA08879E
- Cis-stilbene glucoside in Polygonum multiflorum induces immunological idiosyncratic hepatotoxicity in LPS-treated rats by suppressing PPAR-γ.pubmed:28649126
- Soy isoflavone genistein attenuates lipopolysaccharide-induced cognitive impairments in the rat via exerting anti-oxidative and anti-inflammatory effectspubmed:29102164
- Melatonin balance the autophagy and apoptosis by regulating UCP2 in the LPS-induced cardiomyopathyPubmed:29547569
- Naringenin ameliorates learning and memory impairment following systemic lipopolysaccharide challenge in the ratPubmed:29518393
- Targeted inhibition of tumor survival, metastasis and angiogenesis by Acacia ferruginea mediated regulation of VEGF, inflammatory mediators, cytokine profile and …Pubmed:29678767
- The Association between Inflammatory Markers (iNOS, HO-1, IL-33, MIP-1β) and Depression with and without Posttraumatic Stress Disorder10.1016:j.pharep.2018.06.001
- Diallyl sulfide alleviates cisplatin‐induced nephrotoxicity in rats via suppressing NF‐κB downstream inflammatory proteins and p53/Puma signalling pathwayPubmed:29266336
- Stężenia śródbłonkowej i indukowalnej formy syntazy tlenku azotu w surowicy krwi kobiet ciężarnych palących tytoń–badania wstępne
- Exosome swarms eliminate airway pathogens and provide passive epithelial immunoprotection through nitric oxidePubmed: 30442371
- Trigonelline protects hippocampus against intracerebral Aβ (1–40) as a model of Alzheimer's disease in the rat: insights into underlying mechanismsPubmed: 30421246
- Intraphagolysosomal conditions predispose to Staphylococcus epidermidis small colony variants persistence in macrophagesPubmed: 30412620
- Tadalafil Preserves Penile Nitric Oxide Synthase from Detrimental Effect of Paroxetine in RatsDoi: 10.5152/eurasianjmed.2018.18160
- Macrophage expression of E3 ubiquitin ligase Grail protects mice from lipopolysaccharide-induced hyperinflammation and organ injuryPubmed: 30571701
- Influence of Active Exposure to Tobacco Smoke on Nitric Oxide Status of Pregnant WomenPubmed: 30513890
- Complex interaction of dietary fat and Alaskan bog blueberry supplementation influences manganese mediated neurotoxicity and behavioral impairments
- Silica nanoparticles trigger the vascular endothelial dysfunction and prethrombotic state via miR-451 directly regulating the IL6R signaling pathwayPubmed: 30975181
- ВЛИЯНИЕ ИНДУЦИБЕЛЬНОЙ NO-СИНТАЗЫ НА ТОНУС КОРОНАРНЫХ СОСУДОВ, СОКРАТИТЕЛЬНУЮ ФУНКЦИЮ МИОКАРДА И МЕХАНИЗМЫ …
- Whitening effects of cosmetic formulation in the vascular component of skin pigmentationPubmed: 31074159
- Benzimidazole Derivative, 2-ETH Prevents Poststressor Disorders of Coronary Vascular Tone and Myocardial Contractility
- Cilostazol mitigates mesenteric ischemia/reperfusion-induced lung lesion: Contribution of PPAR-¦Ã, NF-¦ÊB, and STAT3 crosstalk33310046
- Correlation analysis of the proportion of monocytic myeloid-derived suppressor cells in colorectal cancer patients33370317
- Targeting NF-¦ÊB mediated cell signaling pathway and inflammatory mediators by 1, 2-diazole in A549 cells in vitro33598414
- Paeonol Protects Against Intrastriatal 6-Hydroxydopamine Rat Model of Parkinson's Disease33995926
- Cordyceps cicadae NTTU 868 Mycelium with The Addition of Bioavailable Forms of Magnesium from Deep Ocean Water Prevents the A¦Â40 and Streptozotocin?¡
- Ya?lanma ve Hipertansiyonda Yeni bir Endoltelyal Disfonksiyon Belirteci: ??z¨¹nebilir Lektin Benzeri Okside D¨¹?¨¹k Dansiteli Lipoprotein-1
- Cordyceps cicadae NTTU 868 Mycelium with The Addition of Bioavailable Forms of Magnesium from Deep Ocean Water Prevents the A¦Â40 and Streptozotocin-Induced Memory Deficit via Suppressing Alzheimer¡¯s Disease Risk Factors and Increasing Magnesium Uptake of Brain
- Study of cardioprotective activity of the methanolic extract of the aerial parts of Bauhinia madagascariensis compared to Bauhinia purpurea against adrenaline …34167392
- The Effects of Intermittent Hypoxic–Hyperoxic Exposures on Lipid Profile and Inflammation in Patients With Metabolic Syndrome34513946
- Erinacine A-Enriched Hericium erinaceus Mycelium Delays Progression of Age-Related Cognitive Decline in Senescence Accelerated Mouse Prone 8 (SAMP8) Mice34684662
- Whole-Body Cryotherapy Increases the Activity of Nitric Oxide Synthase in Older Men34356664
- Carvacrol hinders the progression of hepatic fibrosis via targeting autotaxin and thioredoxin in thioacetamide-induced liver fibrosis in rat34155936
- Post-stroke treatment of storax improves long-term outcomes of stroke in rats34343648
- A multidimensional strategy for uncovering comprehensive quality markers of Schisandra chinensis (Turcz.) Baill based on pharmacodynamics and chemical …